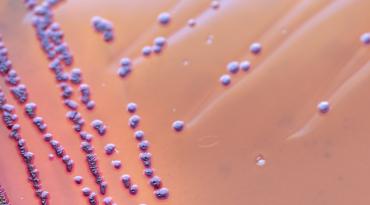
Bactérie

Les "Point sur"
En complément de la veille sanitaire internationale qui se traduit par la publication bi-mensuelle d’un bulletin, le BuSCA, des notes synthétiques de vulgarisation sont rédigées pour fournir des informations en lien avec la surveillance de la chaîne alimentaire et ainsi « faire le point sur » un danger spécifique (e.g. les arcobacters, les PFAS, la ciguatera, les encéphalites à tiques), une épidémie particulière (e.g. Escherichia coli O157:H7 dans les salades en 2019, listériose entre 2017 et 2019…), un outil de surveillance (e.g. le RASFF), une notion (e.g. la spéciation des éléments-traces métalliques, le DALY), un défi analytique (e.g. WGS) etc. Elles s’appuient sur les connaissances disponibles au moment de leur rédaction et peuvent faire l’objet d’une actualisation en cas d’évolution importante de celles-ci.
Groupes de Travail
Membres du Copil